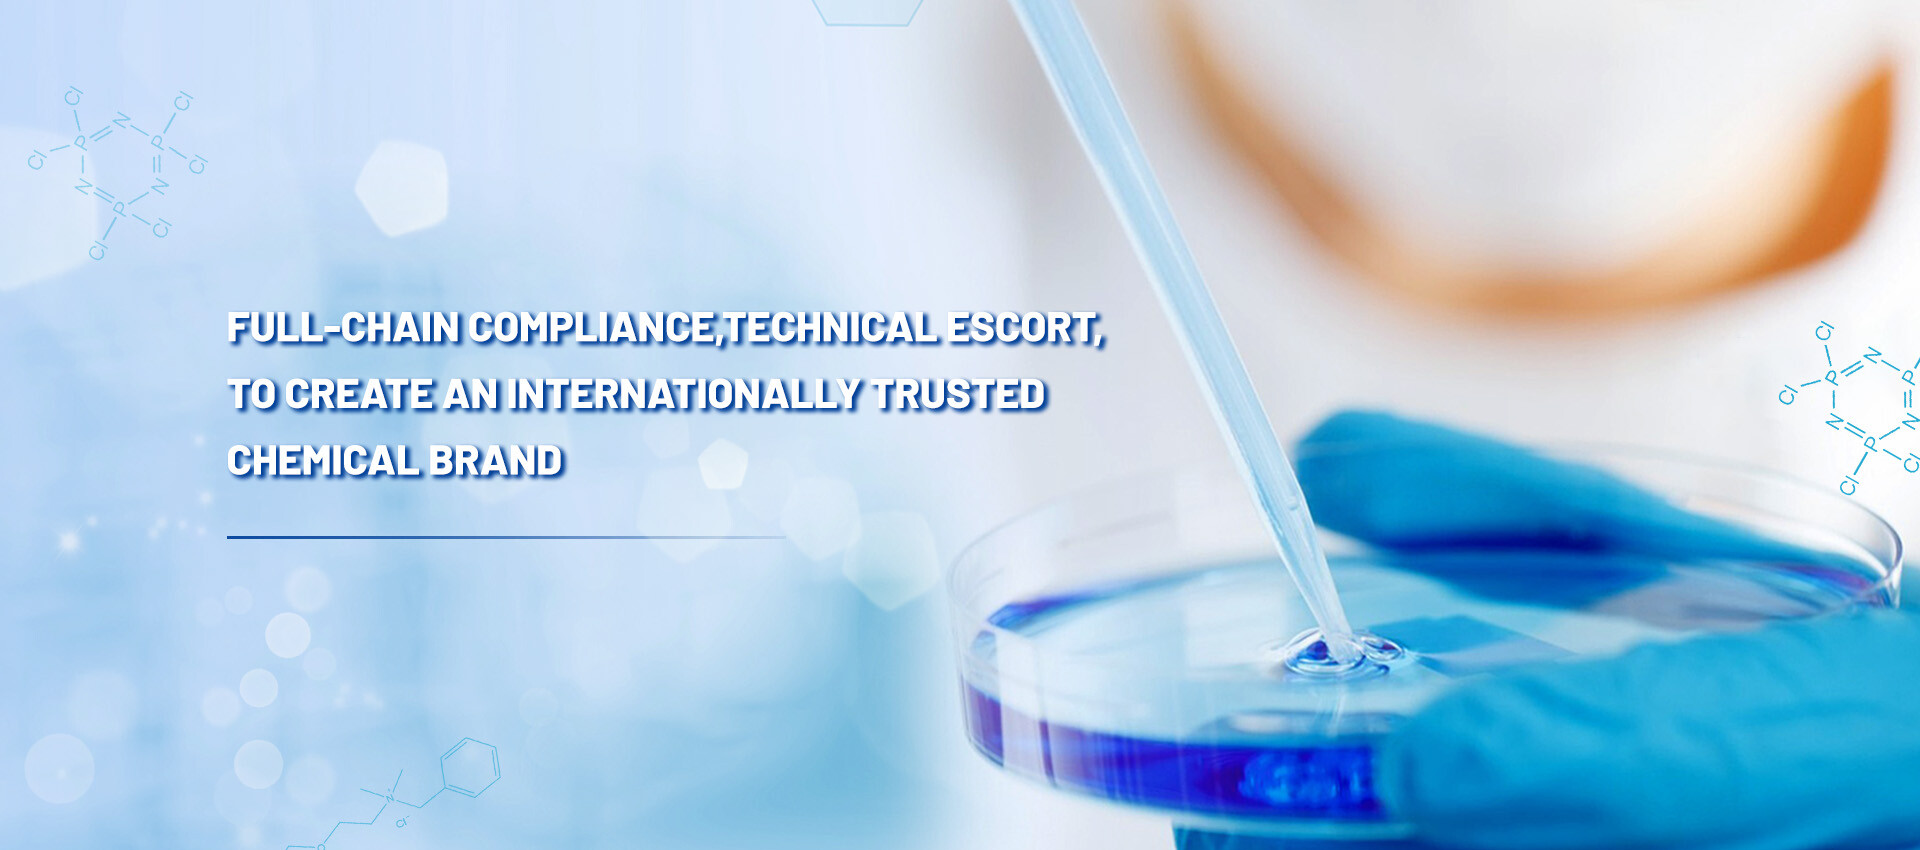
3.jpg

EXPLORE OUR PRODUCTS
Mainly engaged in fine chemical products such as hexachlorocyclotriphosphazene and benzethonium chloride, which are widely used in flame retardant raw materials, polyphosphazene raw materials, medicine, pesticides, materials science and other fields.
Application
It is widely applied in various fields such as flame-retardant raw materials, polyphosphazene raw materials, pharmaceuticals, pesticides, and materials science.
WHY CHOOSE US?
It is a comprehensive enterprise integrating hazardous chemical management, construction engineering construction, chemical product trade and technical services.
Deep production background
The company has more than 10 years of factory production experience and has accumulated rich process experience and management experience in long-term production practice. For the production process of various products, from the screening of raw materials, the control of production processes, to the quality inspection of products, a set of standardized and refined operation procedures have been formed to ensure that every product can meet high quality standards.
High-quality
product quality
In the process of product procurement and sales, the company has established a strict quality control system. From supplier screening to product warehousing, and then to sales and delivery, each link is strictly tested to ensure that the products provided to customers meet high quality standards.
Strong supply chain integration capabilities
Relying on the advantages of Shandong Chemical Industry Base, integrate upstream and downstream resources to ensure stable supply and cost competitiveness.
Professional
service team
The company has a professional service team, including technical personnel, sales personnel and after-sales service personnel.
Zibo Tongzhan International Trade Co., Ltd. was established in 2015. It is a comprehensive enterprise integrating hazardous chemical management, construction engineering construction, chemical product trade and technical services. Based in the core area of China's chemical industry and relying on the rich industrial resources of Zibo City, the company focuses on providing high-quality chemical products, professional technical services and safe and efficient supply chain solutions to global customers. The company has multiple certifications such as hazardous chemical management license and import and export qualifications. It strictly abides by national laws and regulations and is committed to providing safe, efficient and innovative chemical solutions to domestic and foreign customers, becoming a trustworthy international chemical service provider.
NEWS AND EVENTS
We dedicate to make every details better than we could do.